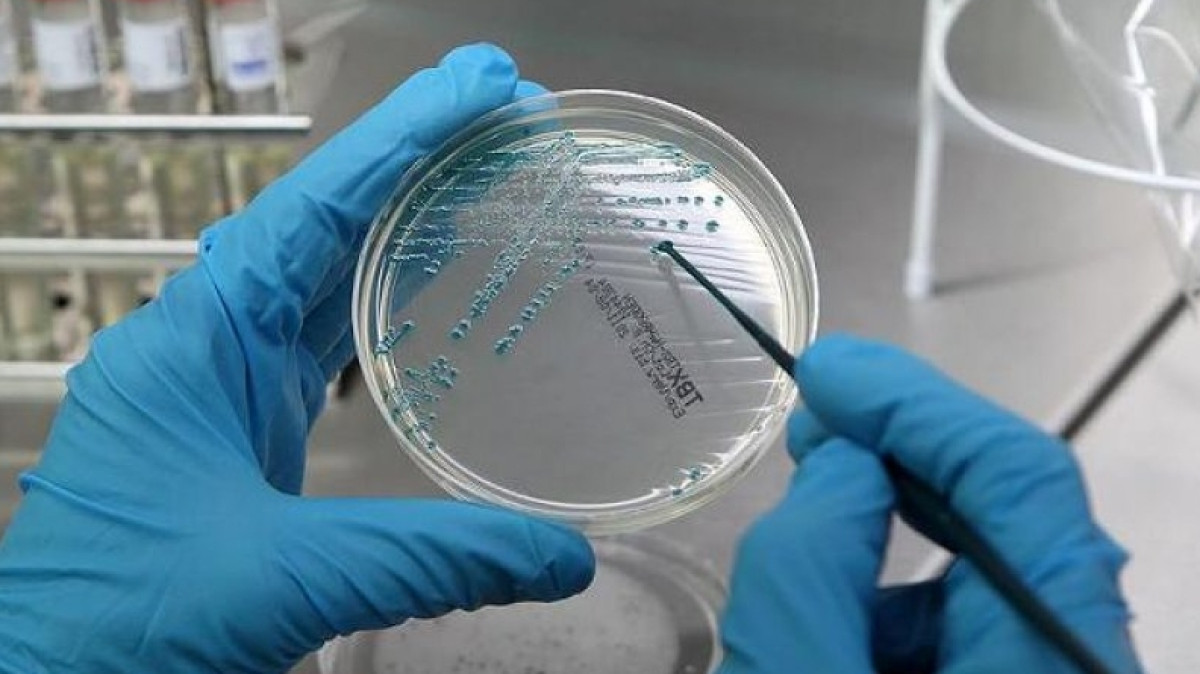
из открытых источников

В поезде сообщением Уральск – Алматы обнаружили четыре факта кишечной палочки, передаёт корреспондент BNews.kz со ссылкой на Первый канал "Евразия".
Поезд Уральск - Алматы проверяли прокуроры. Всего было зафиксировано четыре факта кишечной палочки. Как выяснилось, причина в некачественной уборке. Случившееся рассмотрели на Совете по этике Западно-Казахстанской области и решили, что проблема - в людях, а точнее в их некомпетентности.
"Совет рекомендовал привлечь Батырова, руководителя управления охраны общественного здоровья на транспорте, к дисциплинарной ответственности в виде строгого выговора за ненадлежащее исполнение своих обязанностей и отсутствие должного контроля за работой подчинённых", - сказал председатель Совета по этике Болат Исаков.
Айткали Батыров в своё оправдание заявил, что брать пробы в вагонах его подчинённые имеют право только тогда, когда поезд находится на стоянке, а этого времени недостаточно для тщательной проверки.
"Раз в пассажирском поезде едут люди, то обязательно там эта кишечная палочка присутствует. Я не собираюсь оспаривать, правильно или неправильно мне объявили выговор. Нужно было привлечь проводников этих вагонов, начальника поезда и само юридическое лицо за отсутствие контроля надлежащего, за качество проведения уборки", - ответил на выговор руководитель управления охраны общественного здоровья на транспорте Уральска Айткали Батыров.
После подобных случаев, Комитет транспорта МИР РК провёл соответствующие проверки. По результатам, было выявлено 260 нарушений.
"Проверено около 27 поездов всех перевозчиков. Выявлено 260 нарушений, в том числе выявлены нарушения неисправности систем кондиционирования, внутреннего оборудования, санитарного состояния, в том числе и постельного белья. Выставлены штрафные санкции на 12 млн тенге", - руководитель Управления железнодорожного транспорта Комитета транспорта МИР РК Данияр Коспабаев.
 Тамила Языкова
Тамила Языкова